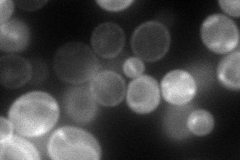
YJL198W
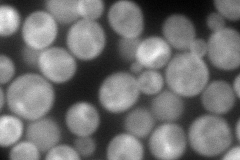
YJL198W
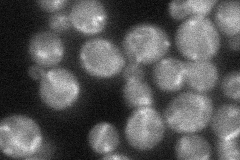
YJL198W
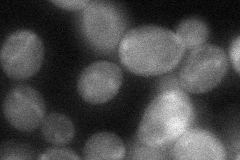
YJL198W

View description
Low-affinity phosphate transporter; deletion of pho84, pho87, pho89, pho90, and pho91 causes synthetic lethality; transcription independent of Pi and Pho4p activity; overexpression results in vigorous growth
Localization:
Intensity:
Fold change:
Significance:
-
C’ GFP library in SD

below threshold13.94 -
N' NOP1pr-GFP in SD
cell periphery,punctate107.263 -
N' TEF2pr-mCherry in SD
cytosol249.335 -
N' NATIVEpr-GFP in SD
punctate,mitochondria49.3434 -
N' TEF2pr-VC and Cyto-VN in SD
cytosol54.0467 -
C’ GFP library in SD+DTT

cytosol15.041.07No -
C’ GFP library in SD+H2O2

cytosol14.431.03No -
C’ GFP library in Starvation Media

cytosol16.611.19No -
C’ GFP library on the background of Pup2-DaMP

N/A -
C’ GFP library on the background of CCT mutant

N/A0N/AYes
